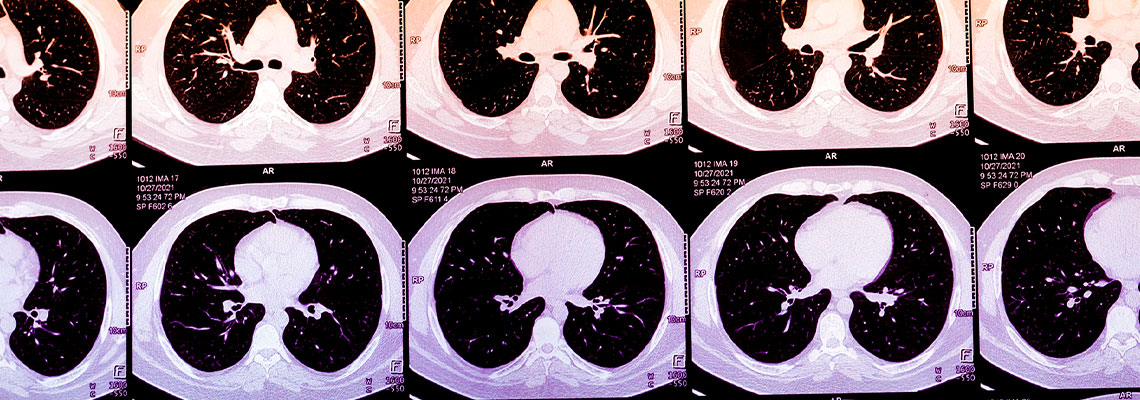
Inteligência Artificial pode prever um ataque cardíaco

Apesar de todas as maravilhas modernas da cardiologia, ainda temos dificuldade em prever quem terá um ataque cardíaco. Muitas pessoas nunca são submetidas a qualquer tipo de rastreio. Agora, startups como Bunkerhill Health, Nanox.AI e HeartLung Technologies estão aplicando algoritmos de IA para examinar milhões de tomografias computadorizadas em busca de sinais precoces de doença cardíaca. Essa tecnologia pode representar um avanço para a saúde pública, ao aplicar uma ferramenta antiga para identificar pacientes cujo alto risco de ataque cardíaco está escondido em plena vista. Mas ela ainda não foi comprovada em larga escala e levanta questões espinhosas sobre a implementação e até mesmo sobre como definimos doença.
No ano passado, estima-se que 20 milhões de americanos tenham feito tomografias computadorizadas de tórax, após um evento como um acidente de carro ou para rastreio de câncer de pulmão. Frequentemente, elas mostram evidências de cálcio nas artérias coronárias (CAC), um marcador de risco de ataque cardíaco, que fica escondido ou não é mencionado em um laudo de radiologia focado em descartar lesões ósseas, traumas internos com risco de vida ou câncer.
Os testes específicos para CAC continuam sendo um método subutilizado de prever o risco de ataque cardíaco. Ao longo de décadas, a placa nas artérias do coração percorre o seu próprio ciclo de vida, endurecendo de resíduo rico em lipídios até se transformar em cálcio. Os ataques cardíacos em si normalmente ocorrem quando uma placa mais jovem e rica em lipídios se rompe de forma imprevisível, desencadeando uma cascata de coagulação e inflamação que acaba por bloquear o suprimento de sangue ao coração. A placa calcificada é geralmente estável, mas encontrar CAC sugere que também é provável que haja placa mais jovem, com maior propensão à ruptura.
O cálcio em artérias coronárias muitas vezes pode ser visto em tomografias de tórax, e a sua concentração pode ser descrita de forma subjetiva. Normalmente, quantificar o escore de CAC de uma pessoa envolve obter uma tomografia computadorizada específica do coração. Algoritmos que calculam escores de CAC a partir de tomografias de tórax de rotina, porém, poderiam ampliar de forma massiva o acesso a essa métrica. Na prática, esses algoritmos poderiam ser usados para alertar pacientes e seus médicos sobre escores anormalmente altos, incentivando-os a buscar cuidados adicionais. Hoje, a presença das startups que oferecem escores de CAC derivados de IA ainda não é grande, mas está crescendo rapidamente. À medida que o uso aumenta, esses algoritmos podem identificar pacientes de alto risco que tradicionalmente passam despercebidos ou que estão na margem do sistema de cuidados.
Historicamente, as tomografias para CAC eram consideradas de benefício marginal e eram vendidas para pessoas saudáveis, mas preocupadas. Mesmo hoje, a maior parte das seguradoras de saúde não cobre esse exame. As atitudes, porém, podem estar mudando. Mais grupos de especialistas vêm endossando os escores de CAC como uma forma de refinar as estimativas de risco cardiovascular e convencer pacientes céticos a começar a tomar estatinas.
A promessa dos escores de CAC derivados de IA faz parte de uma tendência mais ampla de explorar grandes volumes de dados médicos para identificar doenças que, de outra forma, passariam despercebidas. Mas, embora pareça promissora, essa prática levanta muitas questões. Por exemplo, os escores de CAC não se mostraram úteis como um instrumento simples para rastreio universal. Um estudo dinamarquês de 2022 que avaliou um programa populacional, por exemplo, não mostrou benefício nas taxas de mortalidade para pacientes que haviam feito exames de rastreio com CAC. Se a IA fornecesse automaticamente essa informação, o cálculo realmente mudaria?
E, com a adoção generalizada, escores anormais de CAC se tornarão comuns. Quem faz o acompanhamento desses achados? “Muitos sistemas de saúde ainda não estão preparados para agir diante de achados incidentais de cálcio em larga escala”, diz Nishith Khandwala, cofundador da Bunkerhill Health. Sem um procedimento padrão para isso, ele afirma, “corre-se o risco de criar mais trabalho do que valor”.
Também há a questão de saber se esses escores gerados por IA realmente melhorariam o cuidado ao paciente. Para um paciente sintomático, um escore de CAC igual a zero pode oferecer uma falsa sensação de segurança. Para o paciente assintomático com um escore de CAC elevado, os passos seguintes continuam incertos. Para além das estatinas, não está claro se esses pacientes se beneficiariam ao iniciar medicamentos caros para redução do colesterol, como o Repatha ou outros inibidores de PCSK9. Isso pode incentivar alguns a buscar procedimentos desnecessários, porém custosos, que podem até acabar causando danos. Atualmente, a pontuação de CAC derivada de IA não é reembolsada como um serviço separado pelo Medicare ou pela maioria das seguradoras. O caso de negócio para essa tecnologia hoje, efetivamente, está ancorado nesses potenciais incentivos perversos.
Em um nível fundamental, essa abordagem pode realmente mudar a forma como definimos doença. Adam Rodman, hospitalista e especialista em IA no Beth Israel Deaconess Medical Center, em Boston, observou que escores de CAC derivados de IA compartilham semelhanças com o “incidentaloma”, um termo cunhado na década de 1980 para descrever achados inesperados em tomografias. Em ambos os casos, o padrão normal de diagnóstico — no qual médicos e pacientes deliberadamente iniciam exames para descobrir o que está causando um problema específico — foi fundamentalmente rompido. Mas, como Rodman observa, os incidentalomas ainda eram encontrados por humanos que analisavam as imagens.
Agora, ele diz, estamos entrando numa era de “nosologia baseada em máquinas”, na qual algoritmos definem doenças segundo os seus próprios critérios. À medida que as máquinas fazem mais diagnósticos, elas podem identificar coisas que nós deixamos passar. Mas Rodman e eu começamos a nos perguntar se pode surgir um futuro diagnóstico em duas camadas, no qual os “que têm” pagam por algoritmos de marca, enquanto os “que não têm” se contentam com alternativas inferiores.
Para pacientes sem fatores de risco ou desconectados do cuidado médico regular, um escore de CAC derivado de IA poderia potencialmente detectar problemas mais cedo e mudar completamente o panorama. Mas como esses escores chegam às pessoas, o que se faz com eles e se eles podem, de fato, melhorar os resultados dos pacientes em larga escala permanecem questões em aberto. Por enquanto — segurando a caneta enquanto alternam entre pacientes e resultados algorítmicos — os clínicos ainda importam.